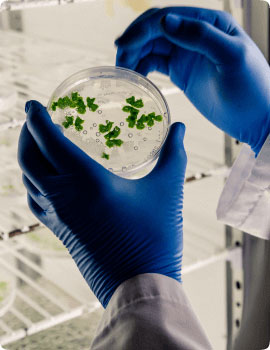

Envisioning tomorrow, Shaping the future
Located in Yantai, Shandong Province, Long Yixing Chemicals Co., Ltd is a company that has more than 10 years of production and sales experience in thermoplastic elastomers industry.
Our company focuses on the production, research and development of TPU/TPE/TPV/TPR and other thermoplastic elastomers, which are widely used in 3C electronics, medical health, automobile manufacturing, sports, industrial equipment, green energy, 3D printing and other fields.
We have provided cost-effective products, customized product solutions and high-quality e-commerce services to customers in Asia, Europe and America. With high average transaction value, high repurchase rate and high customer satisfaction, we have been recognized by many customers.
What makes us proud at Long Yixing?
Providing high level products, advancing forward to be a company esteemed by all stakeholders for its quality and innovation.
But it's not just what we do, it's how we do it.
Honest and ethical
Learning from our mistakes
Embody integrity in our every interaction
Maintain high standards
Be thoughtful
Create sustainable solutions that improve quality of life and meet the changing needs of our customers.
Lead thermoplastic elastomers industry in innovations that advance modern living and a better future.
Put customers at the heart of everything
Be respectful and inclusive
Care for one another and work together
Embracing ownership of our work
Take accountability and get things done

At Long Yixing, we are a group of problem solvers who create products and solutions using our deep experience and understanding of materials science. We strive to lead our industry while delivering best-in-class performance.
Progress starts with listening. We understand that in a world with many challenges there will also be differences of opinion. We respect the diversity and exchange of ideas.
With a long term of expertise providing robust quality control, testing, and comprehensive technical support, Long Yixing is a trusted partner who drives efficiency and success for its customers. Focusing on getting customers what they need, when they need it, Long Yixing goes above and beyond to make products available.